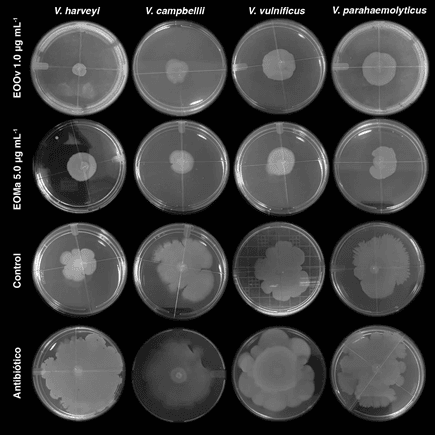

Por: Cristóbal Domínguez-Borbor, Aminael Sánchez-Rodríguez, Stanislaus Sonnenholzner, y Jenny Rodríguez*
A pesar de su importante crecimiento, la industria camaronera se ha visto constantemente afectada por patógenos virales y bacterianos. Recientemente, se ha informado de la aparición de nuevas cepas de Vibrio altamente virulentos, capaces de causar graves mortalidades dentro de la industria camaronera. La mayoría de las cepas de patógenos de Vibrio han mostrado resistencia a los antibióticos comunes, lo que dificulta su control en los sistemas de producción acuícola. En gran medida, la aparición de cepas resistentes se debe al mal uso de antibióticos, comúnmente adoptados por los productores para tratar la vibriosis.
Una estrategia prometedora de bajo riesgo y respetuosa con el medio ambiente es la terapia anti-virulencia. Esta se basa en la interrupción de la comunicación bacteriana, conocida como detección de quórum (DQ). Minimiza el riesgo de resistencia microbiana ya que inhibe la viralización sin afectar el crecimiento bacteriano. Las bacterias se comunican a través de DQ utilizando pequeñas moléculas químicas llamadas autoinductores y adquieren comportamientos colectivos para regular la expresión de varios factores de viralización.
DQ está involucrado en factores tales como: producción de bioluminiscencia, desarrollo de biopelículas, producción de exopolisacáridos, motilidad de enjambre, transferencia de plásmidos, producción secundaria de metabolitos y en interacciones con el huésped y otros microbios.
Es bien sabido que la bioluminiscencia, la formación de moléculas, la motilidad de enjambre y la producción de toxinas en las especies de Vibrio, están mediadas por el sistema DQ para distinguir entre alta o baja densidad de población y coordinar la expresión genética de toda la comunidad.
“Los Vibrios pueden lanzar un ataque coordinado que facilita la superación de las barreras de defensa del anfitrión gracias a los mecanismos mediados por DQ.“
DQ se ha relacionado con la viralización de Vibrios patógenos importantes para la acuicultura. Evitar la comunicación de los Vibrio so alterar sus respuestas son estrategias atractivas para reducir o incluso abolir su viralización.
Los productos naturales, específicamente los aceites esenciales (EOS) en dosis subletales, pueden alterar el sistema DQ y, por lo tanto, la viralización de las bacterias patógenas. Los EOS se han propuesto recientemente como una alternativa eficaz y segura para el reemplazo de antibióticos. El propósito de este estudio fue identificar EOS que pueden interferir con el DQ de Vibrios patógenos conocidos en el cultivo de P. vannamei.
Evaluación de cepas bacterianas, condiciones de crecimiento y aceites esenciales
En este estudio se utilizaron cuatro Vibrios, V. harveyi (cepa E22), V. campbellii (tinción LM2013), V. parahaemolyticus (cepa ATCC 27969) y V. vulnificus (cepa S2). Todas las cepas se cultivaron aeróbicamente en agar Luria Bertani. Se evaluaron cinco aceites esenciales (EOS), aceite esencial de Organum vulgare (EOOv), Melaleuca alter- nifolia (EOMa), Cymbopogon citratus (EOCc), Cinnamomum verum (EOCv) y Thymus vulgaris (EOTv). Para los ensayos anti-DQ, se emulsionaron los EOS.
Se determinaron los valores de concentración mínima inhibitoria (MIC) y concentración bactericida mínima (MBC) de EOS para establecer dosis subletales, afectando solo los indicadores DQ de bioluminiscencia, desarrollo de biofilm y motilidad de enjambre, sin afectar la viabi- lidad de los Vibrios. En cada microplaca se incluyó un control positivo (que contenía inoculum pero no AE) y un control negativo (que contenía AE pero no inoculum), además de seis réplicas para cada concentración de EOS y controles.

Efecto de los EOS sobre la bioluminiscencia y la formación de biopelículas
Dado que la bioluminiscencia en las especies de Vibrio es uno de los fenotipos controlados por la detección de quórum, examinamos la posibilidad de que el AE pueda afectar la bioluminiscencia en las cepas de V. harveyi y V. campbellii de tipo salvaje. Se evaluó el efecto de los EOS sobre las biopelículas de las cuatro cepas de Vibrio, V. harveyi, V. campbellii, V. parahae molyticus y V. vulnificus. La biomasa del biofilm bacteriano se tiñó con cristal violeta (CV) y se cuantificó espectrofotométricamente.
Se prepararon suspensiones bacterianas para cada cepa de Vibrio y se realizó un control que contenía suspensión bacteriana sin AE con seis réplicas para cada concentración. Las células planctónicas se eliminaron y las biopelículas generadas se lavaron cuidadosamente dos veces. A continuación, las placas se aclararon para eliminar el exceso de tinte y se secaron a temperatura ambiente.
Efecto de los EOS sobre la motilidad del enjambre
También se evaluó el efecto de los EOS sobre la motilidad de enjambre de los cuatro Vibrios después de que el medio LB se enfrió a 45 ± 3° C, los EOS se agregaron por separado a cada concentración a evaluar.
El medio LB se dispensó en placas de Petri y las placas se secaron durante 15 min e inmediatamente después se inoculó el inóculo de Vibrios en el centro de las placas. Las placas se incubaron a 26° C durante 72 h y se midió la migración de la motilidad de enjambre en mm.
“Los productos naturales, específicamente los aceites esenciales (EOS) en dosis subletales, pueden alterar el sistema DQ y, por lo tanto, la viralización de las bacterias patógenas.“
Se comparó la migración de la motilidad en enjambre de los Vibrios tratados con AE con la migración de la motilidad en enjambre de los Vibrios no tratados. Además, también se evaluó el efecto de los EOS sobre la motilidad del enjambre en presencia del antibiótico.
Toxicidad in vitro y en vivo de los EOS
Inicialmente, la toxicidad de los EOS se determinó in vitro. La hemolinfa se extrajo de camarones sanos y luego, se realizó un cultivo primario de hemocitos con sales de Hanks. Los cultivos primarios se incubaron y hubo seis réplicas para cada concentración evaluada.
Para determinar la seguridad de los EOS en vivo, se utilizaron larvas de P. vannamei en tres estadios larvarios, zoea 1 (Z-1), mysis 1 (M-1) y postlarva (PL-3). Las larvas de camarón fueron provistas por un criadero comercial, cada ensayo se llevó a cabo de forma independiente y el agua utilizada en las pruebas se filtró y esterilizó.
Los EOS se aplicaron cada ocho horas en relación al volumen total de agua de cada unidad experimental. Como control, las larvas se incluyeron en las mismas condiciones, pero sin exposición a EOS. Las larvas se controlaron durante 96 h. Adicionalmente, con los datos obtenidos se determinó la dosis causante de 50% de mor- talidad (LD50) para cada estadio larvario de camarón.
Efecto anti-virulencia en vivo de EOS y Efecto de la aplicación de EOS en estanques de engorde de P. vannamei
El efecto antiviral de los EOS se verificó mediante una prueba de provocación con larvas de P. vannamei sanas del estadio. Se preparó el inóculo bacteriano y como control se realizó un cultivo de V. campbellii sin AE.
Se incubaron los matraces de cultivo, se centrifugaron los cultivos, se descartaron los sobrenadantes y se utilizaron las células del sedimento e inmediatamente se inocularon a cada tratamiento asignado. Este bioensayo consideró el 100% de la viralización al inóculo de V. campbellii cultivado sin AE.
Se evaluó el efecto potencial de dos EOS en los sistemas de engorde de la producción de camarón. Cada día, los EOS se incorporaron al alimento peletizado comercial y se suministraron inmediatamente a los estanques asignados. La alimentación diaria se estableció inicialmente en aproximadamente el 3% del peso corporal promedio de los camarones y se ajustó semanalmente en función del consumo de alimento y el crecimiento observado. La supervivencia final del camarón (%), el peso promedio (g), los rendimientos de producción (kg / ha) y el índice de conversión alimenticia (FCR) se evaluaron al momento de la cosecha.
Análisis estadístico
Todos los experimentos se realizaron en seis réplicas, excepto en el bioensayo en estanques de engorde que se utilizaron cuatro réplicas. Los resultados se expresaron como un promedio (± desviación estándar) de las repeticiones.
Se realizaron análisis estadísticos para determinar diferencias significativas utilizando ANOVA de una vía, después de verificar los supuestos de normalidad y homogeneidad de la varianza. Cuando se detectaron diferencias significativas se aplicó un análisis de Dunnett.
Determinación de dosis subletales de EOS e inhibición de la bioluminiscencia
Las EOS exhibieron diferentes valores de MIC y MBC frente a las cuatro cepas de Vibrio evaluadas. Los valores de MIC y MBC fueron más bajos para EOOv y EOMa, lo que demuestra que sus actividades inhibitorias y bactericidas fueron más fuertes en comparación con los otros aceites esenciales evaluados.

Los valores de MIC y MBC se utilizaron como referencia para las pruebas posteriores, y en cada caso, solo se analizaron concentraciones sub-letales por debajo de la MIC. Los resultados que se muestran e indican que ninguno de los EOS afectó el crecimiento de los cuatro Vibrios patógenos a la concentración más alta ensayada.
Sólo EOOv y EOMa redujeron significativamente la bioluminiscencia de V. harveyi y de V. campbellii. El porcentaje de inhibición de la bioluminiscencia en cada cepa bacteriana mostró una marcada dependencia de la concentración para el caso de EOOv y EOMa. EOOv fue el aceite más eficaz para inhibir la bioluminiscencia.
Efecto de los EOS sobre la formación de biopelículas y la motilidad de enjambre
EOOv fue el aceite más eficiente para reducir las biopelículas de los cuatro Vibrios patógenos en más del 50% en cada caso. El antibiótico oxitetraciclina inhibió la formación de biopelículas de Vibrios de manera menos eficiente que los EOS, especialmente en V. parahaemolyticus. La motilidad de enjambre de los cuatro Vibrios patógenos se vio afectada significativamente por los EOS de una manera dependiente de la concentración.
Figura 2. Efecto de los aceites esenciales y la oxitetraciclina sobre la motilidad del enjambre de cepas de Vibrio. Todas las imágenes se registraron después de 72 h de incubación. Las concentraciones ensayadas fueron: aceite esencial de orégano (EOOv) 1.0 μgmL − 1; aceite esencial de árbol de té (EOMa) 5,0 μgmL − 1; antibiótico (oxitetraciclina) 10,0 μgmL-1; control: sin aceite esencial ni antibióticos añadidos
En este ensayo, encontramos que los EOS también afectan la resistencia a los antibióticos. Dado que los EOS disminuyeron la motilidad del enjambre de V. vulnificus, los halos de inhibición de oxitetraciclina en presencia de EOS se mantuvieron hasta el final del experimento 96 h. En el grupo de control, los halos de inhibición se redujeron a medida que pasaban las horas.
Toxicidad in vitro y en vivo de los EOS y efectos beneficiosos de los EOS en estanques de engorde de P. vannamei
Las pruebas de toxicidad en vivo de las EOS revelaron que cuanto más temprano está el estadio larvario, mayor es su susceptibilidad a las EOS. En el estadio zoea, los dos EOS afectaron significativamente la supervivencia en la mayoría de las dosis evaluadas. En cuanto al estadio de misis, los EOS solo mostraron un efecto negativo sobre la supervivencia a las dosis más altas evaluadas.

Se registraron diferencias significativas entre las tasas de mortalidad acumulada de P. vannamei PLs, desafiadas con V. campbellii cultivado en presencia y ausencia de EOS. La supervivencia acumulada y el rendimiento mejoraron significativamente en los estanques tratados con EOOv en ambas dosis evaluadas, en comparación con el grupo de control. Con respecto a la EOMa, solo a la dosis más alta, los rendimientos de supervivencia y producción fueron significativamente más altos en comparación con el grupo de control.
Análisis de resultados
Los EOS tienen una capacidad bien documentada para inhibir el QS en bacterias patógenas humanas y animales. Los resultados que obtuvimos mostraron que EOOv y EOMa son capaces de inhibir los procesos mediados por QS en cuatro Vibrios patógenos relacionados con el cultivo de camarón.
Las observaciones de los ensayos in vitro nos permitieron determinar las dosis activas para las pruebas en vivo, en las que EOOv y EOMa aumentaron significativamente la supervivencia de los camarones desafiados con el patógeno V. campbellii. EOOv y EOMa también mostraron resultados alentadores cuando se utilizaron suplementos alimenticios en estanques de camarones.
“Los resultados que obtuvimos mostraron que EOOv y EOMa son capaces de inhibir los procesos mediados por QS en cuatro Vibrios patógenos relacionados con el cultivo de camarón.“
EOOv y EOMa pudieron inhibir la bioluminiscencia de V. harve- yi y V. campbellii. La producción de bioluminiscencia está regulada positivamente por el QS y participa en el establecimiento del patógeno en el huésped. Los Vibrios luminiscentes se utilizan ampliamente como modelos en la búsqueda de productos anti-QS porque este fenotipo solo se expresa cuando las bacterias alcanzan el quórum. Los EOS (EOOv y EOMa) que afectaron negativamente la producción de bioluminiscencia también demostraron tener efectos sobre la inhibición de la biopelícula en los cuatro Vibrios patógenos estudiados.
Los Vibrios forman biopelículas en las superficies de una losa de cemento, elementos plásticos y acero ampliamente utilizados en los sistemas de cultivo de camarón. La adhesión y proliferación dentro de la biopelícula son mecanismos establecidos de patogénesis e infección de algunas especies de Vibrio en camarones.
Cuando se reduce la capacidad de formación de biopelículas, la resistencia a los antibióticos y el potencial de patogénesis también se reducen en la población de Vibrios de vida libre. Una vez que se establece una biopelícula madura, es muy difícil de eliminar, ya que las bacterias incrustadas en la biopelícula exhiben una resistencia 1000 veces mayor a los agentes antimicrobianos convencionales, limitando así las posibilidades de tratamiento.

Además de las biopelículas, otro aspecto que debe tenerse en cuenta en la colonización de tejidos es la motilidad enjambre, a través de la cual los Vibrios patógenos pueden moverse colectivamente. Los Vibrios son bacterias altamente móviles debido a la rotación de los flagelos que facilitan el movimiento.
Se ha comprobado que la motilidad de enjambre de varios Vibrios patóge- nos de interés acuícola también está regulada positivamente por QS, tal es el caso de V. harveyi, V. campbe- llii, V. lginolyticus.
“Los Vibrios forman biopelículas en las superficies de una losa de cemento, elementos plásticos y acero ampliamente utilizados en los sistemas de cultivo de camarón. La adhesión y proliferación dentro de la biopelícula son mecanismos establecidos de patogénesis e infección de algunas especies de Vibrio en camarones.“
La motilidad de enjambre de los vibriones les per- mite desarrollar una población bacteriana colonial tanto dentro como fuera del hospedador, formar bio- películas y volverse resistentes a los antibióticos. Interferir con la motilidad de enjambre de vibriones es esencial para afectar su viralización.
En este caso, EOOv y EOMa redujeron significativamente la motilidad de enjambre de los cuatro Vibrios patógenos con respecto al grupo de control. Parece que la motilidad del enjambre genera resistencia a los antibióticos, ya que facilita el contacto estrecho de las bacterias con los antibióticos, lo que finalmente se traduce en una mayor resistencia adquirida. La capacidad de los EOS para inhibir la motilidad del enjambre incluso en presencia del antibiótico oxitetraciclina, es un resultado que indica una aplicación adicional de EOS, potenciando la eficacia de los antibióticos.
Conclusiones Generales
Los EOs son sustancias aromáticas y límpidas que pueden obtenerse de diferentes partes de las plantas, y su eficacia viene dada por las proporciones de las moléculas bioactivas pudiendo variar en un amplio y diverso espectro de acción dentro de un mismo género vegetal. Además, los EOS de la misma especie vegetal pueden variar en su composición química, dependiendo de las condiciones ambientales y climáticas en las que crecen, su madurez y el método de extracción.
En este sentido, es importante mencionar que una desventaja del uso de AE para controlar la vibriosis en la cría de camarones es que no tienen una composición estándar. Es recomendable obtener EOS de proveedores garantizados y evaluar la calidad de cada lote mediante pruebas controladas in vitro.
En el presente estudio, el EOOv fue el más eficiente para inhibir los procesos mediados por QS en los cuatro Vibrios evaluados. Lo más probable es que la actividad anti QS observada esté relacionada con las proporciones considerables de carvacrol (45,6%) y de timol (5,2%) presentes en este EOOv. Los EOs se han utilizado ampliamente en la preparación de alimentos y como conservante de alimentos para el consumo humano durante varias décadas. Tanto EOOv como EOMa se probaron en estanques de engorde de camarón y se obtuvieron mayores rendimientos de supervivencia y producción. En ambos ensayos en vivo se obtuvieron mejores resultados con el EOOv. vitro, en el que el EOOv fue más eficaz para detener los indicadores de QS.
Esta es una versión resumida desarrolla- da por el equipo editorial de Panorama Acuícola Magazine del artículo original “Essential oils mediated antivirulence therapy against vibriosis in Penaeus vannamei” escrito por Cristóbal Domínguez-Borbor, Aminael Sánchez- Rodríguez, Stanislaus Sonnenholzner, y Jenny Rodríguez que fue publicado en junio. 2020, por el Aquaculture Journal de Elsevier. La versión original se puede consultar en línea a través del enlace: https://doi.org/10.1016/j.aquaculture.2020.735639
Autor de correspondencia en: Universidad Politécnica ESPOL, Guayaquil, Ecuador. Dirección de correo electrónico: jenrodi@espol.edu.ec



